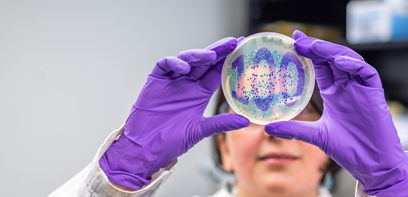
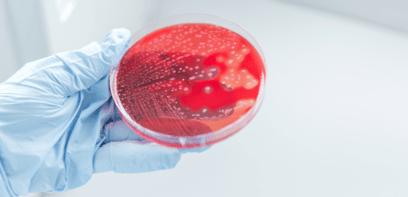

Announcement: Dr. Irene Yang appointed Endowed Chair in Orthopedic Spine & Trauma Biomechanics
December 18, 2024

We are pleased to announce Dr. Irene Yang’s joint appointment as the holder of the newly established Endowed Chair in Orthopedic Spine & Trauma Biomechanics at the Faculty of Engineering and Schulich School of Medicine & Dentistry, Western University, effective January 1, 2025, to December 31, 2029.
Bridging the gap: How a medical student is empowering success for equity-deserving groups
December 17, 2024

Recognized for his research skills, Maud Ahmad, a fourth-year medical student, is also finding new ways to help prospective students pursue their MD dreams.
2024: One year, many milestones
December 12, 2024

Take a minute to celebrate some of the impactful, celebrated and discussed moments of 2024 in this short highlight reel. From groundbreaking research to inspiring personal and community milestones, it has been an amazing year!
PhD candidate confronts schizophrenia and mental health head on
December 11, 2024

PhD candidate Kesavi Kanagasabai wants to confront mental health head-on. She has introduced a new campus program that invites students to talk about their mental health struggles. And, is also creating a tool to improve research on schizophrenia.
Dementia doesn’t have to be your destiny
December 10, 2024

Tackling a list of health and lifestyle factors – like physical inactivity, hearing loss, obesity and hypertension – can go a long way in lowering the risk of dementia, new research says.
Healthy smile, happy life: Does better oral health lead to healthy aging?
December 05, 2024

Backed by new funding from the Canadian Institutes of Health Research (CIHR), a team led by Dr. Noha Gomaa is looking at the impact of access to oral health care on the well-being of older Canadians.
Expert Explainer: Why is a cure for HIV so elusive?
November 29, 2024

Schulich Medicine & Dentistry researchers share progress and challenges in ending the HIV epidemic
Announcement: Dr. Julio Martinez-Trujillo re-appointed Provincial Endowed Academic Chair in Autism
November 29, 2024

I am pleased to announce that Dr. Julio Martinez-Trujillo has been re-appointed as the Provincial Endowed Academic Chair in Autism at the Schulich School of Medicine & Dentistry, Western University. His renewed term will be effective January 1, 2025, to December 31, 2029.
Announcement: Dr. Tamara Van Hooren appointed Associate Dean, Post Graduate Medical Education (PGME)
November 28, 2024

I am pleased to announce that Dr. Tamara Van Hooren has been appointed as the Associate Dean, Post Graduate Medical Education (PGME) at the Schulich School of Medicine & Dentistry, Western University, effective January 1, 2025, to December 31, 2029.
Announcement: Patrick O’Donoghue, PhD, appointed inaugural Huntington Society of Canada Research Chair
November 27, 2024

I am pleased to announce that Patrick O’Donoghue, PhD, has been appointed as the inaugural Huntington Society of Canada Research Chair at the Schulich School of Medicine & Dentistry, Western University, effective November 1, 2024, to October 31, 2029.
Western research centre hosts Healthy Aging Fair
November 22, 2024

The event connects older adults to research, community resources for physical, mental and social wellness
Research community comes together to celebrate the Science of Aging
November 21, 2024

Annual Taylor Prize celebrations recognize the scientific advances helping people live well, longer.
In Memoriam: Dr. John P. Girvin, MD’58
November 13, 2024

It is with great sadness that we announce the passing of neurosurgeon Dr. John P. Girvin on November 12, 2024.
New study aims to develop novel renal preservation method by mitigating ischemic injury and inflammation
November 13, 2024

Third-year medical student Helen Jin is helping combat injury that occurs during pre-transplant preservation in the kidney. It’s work that will improve the success rate of kidney transplants worldwide.
Lack of sleep regulations in Canada’s licensed child-care facilities puts children’s health at risk
November 11, 2024

With no guidance from statutes and inconsistent sleep regulations for licensed child care in Canada, children's daytime sleep needs are being neglected. In an article in the Conversation, Graham Reid, associate professor in the Departments of Psychology and Family Medicine, and team outline the dangers and what can be done to promote optimal sleep habits.
Military experiences help MD student pursue a dream
November 06, 2024

Meet Jessica Ann Girard, one of three students with a military background in Schulich Medicine & Dentistry’s MD Class of 2028. Girard is stepping into a new career in pursuit of a long-held dream to be in medicine.
Exploring economic impact of dementia prevention earns MSc grad Governor General’s Gold Medal
November 06, 2024

With the first-ever Canadian dementia prevention model, Marie Lan, MSc’24, will help assess the economic impact of managing dementia risk factors. She has also earned a Governor General’s Gold Medal in the process.
‘Bilateral cooperation:’ U.S. Consul General Baxter Hunt visits Western
November 05, 2024

Visit outlines the extensive collaboration between Western and U.S. that benefits researchers, students and the public.
Study provides clarity around blood pressure management in non-cardiac surgery
November 04, 2024

A large-scale trial, led by Dr. Amit Garg, found no significant difference in the risk of kidney injury between two approaches for blood pressure management.
Student researcher targets life-saving treatments for life-threatening lung condition
October 31, 2024

Leela Raj, a third-year medical student at Schulich Medicine & Dentistry, is working to improve the outcomes for those living with a life-threatening lung condition.
Western students win international undergraduate competition
October 31, 2024

"I’m not interested in doing research just for the sake of doing research. I want to see it have an impact." And it is. As a Global Undergraduate Awards winner, Diana Urian, BSc'24, is giving us a better view of functional decline in Alzheimer's patients.
Study explores ways to prevent opioid poisoning in children
October 30, 2024

First-of-its-kind Canadian study found 10 Ontario children died of an opioid-related cause between 2017 and 2021.
Western researchers closing in on treatment for long COVID
October 28, 2024

Two new projects funded by the Schmidt Initiative for long COVID, and led by Schulich Medicine & Dentistry Professor Douglas Fraser, investigate drug treatments and patients most likely to suffer from the condition.
Announcement: Brad Urquhart, PhD, re-appointed as the Associate Dean, Basic Medical Sciences Undergraduate Education
October 24, 2024

I am pleased to announce that Brad Urquhart, PhD, has been re-appointed as the Associate Dean, Basic Medical Sciences Undergraduate Education (BMSUE) at the Schulich School of Medicine & Dentistry, Western University, effective September 1, 2025, to August 31, 2030.
Curbing the addiction: Pioneer study explores CBD’s potential to reduce opioid use after knee surgery
October 23, 2024

Joel Gagnier, and a team from the University of Michigan, are undertaking a large-scale study to determine the effectiveness of cannabidiol in reducing pain after knee replacements.
Resilience part of the path to medicine for PhD graduate
October 22, 2024

Michael Roes has not let setbacks slow him down in the path to becoming a physician. Find out more about this soon-to-be PhD graduate, marathon runner and future physician on the eve of fall convocation.
A life with deep purpose: Thanks to donors, student-athlete Jackson Findlay has big ambitions
October 22, 2024

Coming to Western fulfilled two of Jackson Findlay’s dreams – to play for the best football team in the country and study at a world-renowned medical school. Donor generosity is the key to making those dreams a reality.
Announcement: Dr. Louise Moist appointed William F. Clark Chair in Nephrology
October 22, 2024

I am pleased to announce that Dr. Louise Moist has been appointed as the William F. Clark Chair in Nephrology, effective September 14, 2024, to August 31, 2029.
Study shows playing video games may improve cognitive performance
October 18, 2024

While relatively little is known about how the brain and body affect each other, research by Neuroscientist Adrian Owen is shedding light on how gaming and exercise affect our cognitive abilities.
MPH grad Netri Kalra takes on new career challenges in NWT
October 18, 2024

Netri Kalra graduates from the Master of Public Health Program during Western’s fall convocation. Now she is making a difference in Yellowknife, NWT, including studying the effect of wildfires on water quality.
Announcement: Dr. Patricia Hall as interim Chair, Department of Psychiatry - Extension
October 16, 2024

I am pleased to announce that Dr. Patricia Hall’s appointment as interim Chair, Department of Psychiatry at the Schulich School of Medicine & Dentistry, Western University, has been extended. The extended term will be effective January 1, 2025, to December 31, 2025, or until a permanent Chair is appointed.
What you need to know about cold and flu season
October 15, 2024

Each year we face a new version of the flu, a virus that seems to mutate constantly. So how do we protect ourselves against this virus that can hit hard? Jennifer Guthrie, PhD, and assistant professor in the Department of Microbiology and Immunology, gives us a preview of what to expect this flu season, and how to take steps to guard against infection.
Exploring the science that’s helping us live better, longer
October 09, 2024

A new podcast on the Science of Aging, produced by Schulich Medicine & Dentistry, features stimulating discussions with leading Western University researchers who are redefining what it means to get older.
Return-to-office mandates may not be the solution to downtown struggles that Canadian cities are banking on
October 07, 2024

Will return-to-work mandates help improve productivity and boost business recovery? Jamie Seabrook, PhD, professor in the Departments of Epidemiology and Biostatistics and Paediatrics, and team have some answers in this article in the Conversation.
Announcement: Dr. P. Andrea Lum as Vice Dean, Clinical Faculty Affairs - Extension
October 04, 2024

I am pleased to announce the extension of Dr. P. Andrea Lum’s appointment as Vice Dean, Clinical Faculty Affairs at the Schulich School of Medicine & Dentistry, Western University. Dr. Lum’s extended term will be effective January 1, 2025, to December 31, 2025.
Sniffing out better care: Researchers bringing relief for distorted smell disorder triggered by COVID-19
October 03, 2024

Dr. Leigh Sowerby and researchers at St. Joseph’s Health Care London are testing a novel treatment for a debilitating post-COVID-19 smell disorder
Resiliency and concussion: Why do some athletes develop neurodegeneration and others don’t?
October 03, 2024

In the wake of National Football League Hall of Famer Brett Favre's revelation that he has Parkinson's disease, Ravi Menon, PhD, writes in the Conversation that a concussion might be considered a "mild" injury, but its effects can last a lifetime.
Common gynaecological surgery for abnormal bleeding associated with a high risk of hysterectomy
October 02, 2024

Researchers from ICES, the Schulich School of Medicine & Dentistry and Lawson Health Research Institute provide new directions for counselling patients about outcomes
Announcement: Dr. Matthew Weir appointed as Dr. Adam Linton Chair in Kidney Health Analytics
October 02, 2024

I am pleased to announce that Dr. Matthew Weir has been appointed as the Dr. Adam Linton Chair in Kidney Health Analytics at the Schulich School of Medicine & Dentistry, Western University, effective October 1, 2024, to September 30, 2029.
Rethinking aging: Expert Jane Rylett on empowering vibrant lives beyond 65
September 30, 2024

As the global population ages, the challenges related to health care have never been more significant. Jane Rylett, PhD, a global authority on aging and health care, is committed to shifting the narrative from “chasing youth” to empowering older adults to live vibrant, healthy lives.
MD student striving to improve Indigenous representation and cultural safety in Medicine
September 30, 2024

Taylore Dupuis Shalovsky, a fourth-year medical student, has a goal to become a culturally safe health-care provider. And to teach others to be the same.
Announcement: Dr. Dale W. Laird appointed Acting Chair, Department of Anatomy and Cell Biology
September 27, 2024

I am pleased to announce that Dr. Dale W. Laird has been appointed as Acting Chair, Department of Anatomy and Cell Biology, at the Schulich School of Medicine & Dentistry, Western University, effective October 1, 2024, to June 30, 2025, or until a permanent Chair is appointed, whichever occurs first.
Announcement: Re-appointment of Dr. John Yoo, Dean of Schulich School of Medicine & Dentistry
September 26, 2024

I am very pleased to announce that Dr. John Yoo has been re-appointed Dean, Schulich School of Medicine & Dentistry for a second term, beginning July 1, 2025, through June 30, 2030.
How better community engagement can improve emergency management in Canada
September 26, 2024

Sayra Cristancho, PhD, writes that Canada is the only G7 country without a national health security and emergency agency, leaving communities to scramble just as the number of emergencies and social issues, like homelessness, rises.
Vanier scholar develops innovations for use of AI in cancer treatment planning
September 26, 2024

Edward Wang is using AI to improve and speed up treatment planning for a special type of radiation which can target multiple spots in the lungs.
Fighting the hidden menace: medical students take on the challenge of hypertension
September 24, 2024

A group of medical students is tackling hypertension in the communities where this silent menace that is taking its toll.
Announcement - Dr. Manuel Montero-Odasso appointed as inaugural holder of Wolfe Research Professorship in Aging
September 19, 2024

I am pleased to announce that Dr. Manuel Montero-Odasso, MD, PhD, FRCPC, AGSF, FGSA, has been appointed as the inaugural holder of the Wolfe Research Professorship in Aging at the Schulich School of Medicine & Dentistry, Western University, effective September 1, 2024, to August 31, 2030. This new Professorship was established through a generous gift from an anonymous donor.
Addressing the treatment gap at the intersection of Chronic Kidney Disease and obesity
September 16, 2024

Through her pathway of research, MD student Gurleen Sahi is helping patients with Chronic Kidney Disease and obesity get the care they need.
CIHR funding boost helps answer challenging questions that could save lives
September 11, 2024

Positive results come from 80-per-cent increase in grant applications building on an upward trend, says vice dean of Research & Innovation
Schulich Dentistry student’s research seeks out the ‘essential’ dental plan
September 10, 2024

Joeleen Philip, DDS'26, is taking on many challenges, including determining a public consensus for what constitutes essential oral health care for Canadians. Find out what (and who) inspires this dentistry candidate.
MD student Maryanne Oketch: From winning Survivor to starting medical school
September 09, 2024

Survivor star Maryanne Oketch brings lessons from the reality TV show and a passion for healing to her MD journey.
Announcement: Dr. Walter Rushlow appointed Acting Associate Dean, Basic Medical Sciences Undergraduate Education (BMSUE)
September 09, 2024
I am pleased to announce that Dr. Walter Rushlow has been appointed as Acting Associate Dean, Basic Medical Sciences Undergraduate Education (BMSUE) at the Schulich School of Medicine & Dentistry, Western University, effective September 1, 2024, until August 31, 2025.
From neonatal research to environmental advocacy, BMSc student creates positive change
September 06, 2024

Mehrsa Feizi, a student in Schulich Medicine & Dentistry's Bachelor of Medical Sciences program, is committed to making a positive impact. She is already making a difference in the lives of newborns with necrotizing enterocolitis (NEC) and is also a driving force behind sustainability initiatives on campus.
Royal Society of Canada honours three Western scholars
September 04, 2024

Dr. Richard Kim is among three Western University scholars who have been recognized by the Royal Society of Canada
Student researcher helps in the battle against antibiotic resistance
August 27, 2024

Bacteria and the immune system are in a constant battle in our bodies, and Alex Sheikh, student researcher, is right in the midst of this struggle, looking for ways to help the body win the war against MRSA.
Announcement: Dr. Dale W. Laird re-appointed Assistant Dean, Research Chairs & Awards
August 26, 2024

We are pleased to announce that Dr. Dale W. Laird has been re-appointed as Assistant Dean, Research Chairs & Awards, at the Schulich School of Medicine & Dentistry, Western University, effective September 1, 2024, to June 30, 2027.
Unravelling the aging brain’s secrets earns renowned U.S. neuroscientist prestigious 2024 Taylor Prize
August 19, 2024

For his extraordinary body of work, Rusty Gage, PhD, has been chosen as the 2024 J. Allyn Taylor International Prize in Medicine laureate by Schulich School of Medicine & Dentistry and the Robarts Research Institute at Western University.
Schulich Medicine & Dentistry researchers asked ChatGPT for medical diagnoses. Here’s what they found.
August 16, 2024

Can AI add value to medical education and improve communication between physicians and patients?
Researchers develop new chemical probe as promising tool for drug discovery and therapeutics
August 16, 2024

New research, recently published in Nature Chemical Biology by Caroline Schild-Poulter and her team, is opening doors to innovative treatments for cancer.
Condition first discovered by Schulich Medicine neuroscientist named by scientific community
August 15, 2024

Adrian Owen’s landmark research on consciousness in patients in vegetative state marks milestone.
More doctors to be trained in Sarnia-Lambton, thanks to new partnership
August 14, 2024

Collaboration between Bluewater Health and Schulich School of Medicine & Dentistry, powered by philanthropy, will launch in 2025
In memoriam: Dr. Andrew Edward Jones
August 14, 2024
It is with profound sadness that we announce the passing of Dr. Andrew Edward Jones on Sunday, August 11, 2024, at the age of 52.
CMHF MD student award recipient looks ahead to a career of service
August 08, 2024

Third-year student Iman M’Hiri found her calling as a physician at age five. Now she has her sites set on giving back through a career of compassionate care.
Announcement: Dr. Robin Mackin appointed as Assistant Dean, Learner Experience (UME)
August 08, 2024

I am pleased to announce that Dr. Robin Mackin has been appointed as Assistant Dean, Learner Experience (UME) at the Schulich School of Medicine & Dentistry, Western University, effective August 1, 2024, to July 31, 2029.
Announcement - Dr. Sonja M. Reichert re-appointed as endowed Dr. Brian W. Gilbert Canada Research Chair in Primary Care Research
August 06, 2024

I am pleased to announce that Dr. Sonja M. Reichert has been re-appointed as the endowed Dr. Brian W. Gilbert Canada Research Chair in Primary Care Research at the Schulich School of Medicine & Dentistry, Western University, effective July 1, 2024, to June 30, 2029.
Interconnected crisis: Declining planetary and population health
August 01, 2024

It's called the greatest global health threat to humankind in the 21 century. Schulich Medicine's Dr. Anna Gunz and Lesley Gittings of the Faculty of Health Sciences have partnered to develop a better understanding of how climate change is affecting our health.
Schulich Medicine researchers find over the-counter antioxidant may help counteract mental health effects of cannabis
July 30, 2024

Study shows supplement can mitigate depression, anxiety and ‘amotivation syndrome’ from chronic cannabis use
Announcement: Dr. Abdel-Rahman Lawendy appointed J.C. Kennedy Chair in Orthopaedic Surgery
July 30, 2024
I am pleased to announce that Dr. Abdel-Rahman Lawendy has been appointed as the J.C. Kennedy Chair in Orthopaedic Surgery at the Schulich School of Medicine & Dentistry, Western University, effective July 1, 2024, to June 30, 2029.
Announcement: Dr. Gregory Gloor re-appointed as Chair, Department of Biochemistry
July 30, 2024

I am pleased to announce that Dr. Gregory Gloor has been re-appointed as the Chair of the Department of Biochemistry at the Schulich School of Medicine & Dentistry, Western University, effective from July 1, 2024, to June 30, 2029.
The power of sport: Western Olympians and Paralympian share their stories
July 26, 2024

As the Summer Olympics opens today in Paris, we connected with Western athletes, including our own Dr. Robin Mackin, who shared lessons learned on the international stage.
Schulich Medicine & Dentistry’s Alison Allan appointed associate vice-president (research) at Western
July 23, 2024

Allan will support and expand research in medical and health sciences and seek ways to improve Western's collective research impact.
New neuroscientific techniques may predict survival rates of ICU patients
July 22, 2024

Professor Adrian Owen and team can now better predict brain injury outcomes using multiple neuroimaging techniques.
X-LABS empowers the next generation of scientists
July 17, 2024

Immersive science program opens doors for talented high school students from diverse backgrounds.
Western researchers aim to change contraceptive technology with new iron IUDs
July 16, 2024

Along with Schulich Medicine & Dentistry researchers Dean Betts and Kate Choi, Samantha Gateman, chemistry professor, is determined to find an alternative solution to contraception with challenging side effects.
Announcement: Dr. Cheryl Currie appointed Director of the Interfaculty Program in Public Health
July 16, 2024

I am pleased to announce that Dr. Cheryl Currie has been appointed as the Director of the Interfaculty Program in Public Health at the Schulich School of Medicine & Dentistry, Western University, effective September 1, 2024, to August 31, 2029.
Student researcher brings expertise to Canada to prepare for next pandemic
July 12, 2024

When he received the offer to fly across the world to build a universal COVID-19 vaccine with a researcher at Schulich School of Medicine & Dentistry, Cody Hird didn’t hesitate to pack his bags.
Master’s program provides firsthand look at health-care system in Uganda
July 11, 2024

Noor Qureshi has always had a passion for global health, but visiting Uganda for the first time this spring as part of the Master of Health Sciences (MHSc) in Global Health Systems program gave her a deeper understanding of the challenges faced by those in resource-limited communities.
Research program at Windsor campus marks 10 years of turning students into clinical researchers
July 10, 2024

The Schulich-UWindsor Opportunities for Research Excellence Program (SWORP) is marking its 10th anniversary with grants to 15 medical school students.
Flipping the script: Using simulation to support leaders in creating open conversation
July 09, 2024

A team of researchers, led by Dr. Taryn Taylor from the Department of Obstetrics & Gynecology, is using simulation to support leaders in creating environments of open communication.
Medical Biophysics PhD student joins Nobel Laureates to discuss AI in science
July 05, 2024

Jaryd Christie will share his research on using AI to improve treatment outcomes for lung cancer patients at the 73rd Lindau Nobel Laureate Meeting.
Announcement: Dr. Craig Campbell named the inaugural Children’s Health Foundation Chair in Paediatrics Research
July 05, 2024
I am pleased to announce that Dr. Craig Campbell, MD, MSc, FRCPC, has been named the inaugural Children’s Health Foundation Chair in Paediatrics Research.
Children’s Health Foundation donation propels paediatric research
July 03, 2024

Dr. Craig Campbell is the inaugural holder of the Children’s Health Foundation Chair in Paediatrics Research. A new $3-million endowment will bolster paediatric research by Campbell and other scientists.
Faster, cheaper, more efficient: Building Canada’s capacity for pragmatic clinical trials
July 02, 2024

Dr. Amit Garg is training doctors how to run pragmatic clinical trials and, in the process, helping Canada manage future health threats
Vaccination may reduce memory loss from COVID-19 infections
June 27, 2024

Canada Excellence Research Chair Dr. Robyn Klein and her team's new study identifies one potential mechanism driving COVID-19-induced memory loss and shows that it can be prevented by vaccination
Dental student wins Niagara Ultra’s marathon with fastest time in 10 years
June 27, 2024

Kristian Jamieson is following in the footsteps of ancestor Tom Longboat, as he looks forward to Boston Marathon
Announcement - Dr. Susan Huang appointed the Dr. Robert Lindsay Chair in Dialysis Research and Innovation
June 24, 2024

I am pleased to announce that Dr. Susan Huang has been appointed as the Dr. Robert Lindsay Chair in Dialysis Research and Innovation at the Schulich School of Medicine & Dentistry, Western University, effective September 16, 2024, to September 15, 2029.
Dr. Jane Thornton appointed as new IOC Medical and Scientific Director
June 20, 2024

The Schulich Medicine & Dentistry professor will manage the medical and scientific department while maintaining her academic appointment with the School.
MD program successfully accredited for maximum 8-year term
June 20, 2024

Thanks to the outstanding efforts of the School’s community, the Committee on Accreditation of Canadian Medical Schools voted to continue accreditation for Schulich Medicine & Dentistry’s MD Program for the maximum term of eight years.
Beatboxing dental student finds his rhythm in research
June 19, 2024

When Keng-Shuo (Alex) Pi was eight years old, his growing curiosity for the science of the mouth started to inspire two different passions: Dentistry and beatboxing.
Genetic data study finds positive genetic associations between coffee intake, obesity and substance use
June 18, 2024

Researchers from Schulich Medicine & Dentistry and the University of California San Diego have shown a genetic predisposition for coffee intake.
Alumni of Distinction Award recipients - 2024
June 13, 2024

With pleasure, we announce the 2024 Alumni of Distinction Award recipients, symbolic of the excellence and pride we have in all of our alumni. These people have distinguished themselves as role models both for our alumni and our current students and learners. They are truly an inspiration to us all.
MSc grad braves a world of change to pursue a career in radiopharmacy and neuroscience
June 13, 2024

From pharmacy in Nigeria to conducting research in neuroimagery, Olujide Oyeniran has been on quite a journey. Now, as he graduates with his MSc in Medical Biophysics, he sets his sights on a bright future.
BMSc grad seizes opportunities to learn from leaders and guide young students
June 13, 2024

Guided mentors throughout her academic career, Rose Adibi looks to guide a new generation of students.
Announcement: Dr. Mark Goldszmidt appointed Acting Director of the Centre for Education Research & Innovation (CERI)
June 10, 2024

I am pleased to announce that Dr. Mark Goldszmidt has been appointed Acting Director of the Centre for Education Research & Innovation (CERI) at the Schulich School of Medicine & Dentistry, Western University, effective June 1, 2024, to May 31, 2025.
MD grad advocates for mental wellness across his community
June 07, 2024

As a second-generation Vietnamese Canadian, Andrew Nguyen was inspired to pursue his MD at Schulich Medicine & Dentistry’s Windsor Campus. Learn more about his story.
Grad embraces the many possibilities of trying something new
June 07, 2024

Shaily Brahmbhatt experienced a fascinating collection of firsts. Today as she graduates, she describes her adventures in Schulich Medicine & Dentistry’s MD-MD+ program.
School rolls out “purple” carpet to celebrate awards of excellence
May 29, 2024

Schulich Medicine & Dentistry literally rolled out the purple carpet at a gala evening to celebrate the accomplishments of its community at the 33rd annual Awards of Excellence event.
Grant powers new frugal biomedical innovation training program
May 22, 2024

James Lacefield, PhD, professor in Medical Biophysics at Schulich Medicine & Dentistry and director of the School of Biomedical Engineering, will lead the training of the next generation of pioneers in frugal biomedical innovation thanks to a $1.65-million grant.
Western-led analysis shows potential for new Alzheimer’s treatment
May 21, 2024

Results from phase 2a clinical trial shows early potential for new therapeutic for Alzheimer’s disease
MD admissions changes improve pathways into medical school
May 21, 2024

Changes to admissions processes include new third-year entry program and Black Applicant Pathway.
Western’s Adrian Owen elected Fellow of the Royal Society
May 16, 2024

The professor in cognitive neuroscience and imaging at the Schulich School of Medicine & Dentistry deeply honoured and humbled by global recognition.
Biochemistry – Celebrating a century of groundbreaking research
May 16, 2024
Professor James Bowman was appointed the first professor of what was called Theoretical Chemistry in 1924, and now the Department of Biochmistry is celebrating 100 years of research excellence.
Western researchers’ breakthrough paves way for ALS cure
May 13, 2024

Fueled by a $10-million gift from the Temerty Foundation, a possible new ALS treatment could move to clinical trials within five years
Nicole Campbell receives national honour for making a positive difference in the classroom – and beyond
May 06, 2024

Campbell receives the 3M National Teaching Fellowship Award, honouring exceptional contributions to teaching and learning at the post-secondary level.
New initiative to shield Canada against future pandemics
May 06, 2024

Western’s DELPHI Network one of the 16 primary care electronic medical record networks across the country to enhance early detection and response time.
Students explore careers in medicine at Discovery Day 2024
May 03, 2024

Area high school students come to Western to research careers in medicine and health sciences.
Funding will help expand program, improve recruitment to critical cancer trials
April 30, 2024

Dr. Caroline Hamm, Chair Windsor Oncology, and professor at Schulich Medicine & Dentistry and its Windsor campus, receives funding to expand clinical trial recruitment pilot.
Announcement: Dr. Eldon Loh appointed as Earl Russell Chair in Pain Management
April 30, 2024

I am pleased to announce that Dr. Eldon Loh has been appointed as the Earl Russell Chair in Pain Management at the Schulich School of Medicine & Dentistry, Western University, effective May 1, 2024 to April 30, 2029.
Concussion research helps to protect kids’ brains
April 29, 2024

Research by Ravi Menon, PhD, and team is uncovering new knowledge about the effects of concussion and shaping policies for youth sports.
In a Canadian first, surgical team at London Health Sciences Centre performs robotic assisted spinal surgery
April 26, 2024

The team, led by Schulich Medicine & Dentistry’s Dr. Victor Yang, completed a successful, robotic-assisted direct lateral spine surgery.
Windsor Campus celebrates 2024 Awards of Excellence recipients
April 25, 2024

The Windsor Campus celebrated those who received the 2024 Awards of Excellence – and marked the 13th year honouring the dedication and hard work of those who represent the School’s values.
Announcement - Dr. Kristin Clemens appointed as Diabetes Canada Chair in Diabetes Management
April 22, 2024

Dr. Kristin Clemens has been appointed as the Diabetes Canada Chair in Diabetes Management at the Schulich School of Medicine & Dentistry, Western University, effective March 1, 2024, to February 28, 2029.
PhD candidate presents work at HIV research conference that opens doors to treatment
April 19, 2024

Western researchers taking leading role as Canadian Conference on HIV/AIDS Research brings top experts and community members to London to share scientific advances.
Krembil Foundation funds help researchers investigate role of brain’s immune system in Alzheimer’s
April 18, 2024

Greg Dekaban, PhD, and team received $2.4 million from the Krembil Foundation to investigate the trigger that causes the brain’s immune system to fail to control the brain inflammation that arises in Alzheimer’s disease.
Groundbreaking research paves way to AAAS Fellowship for Western scientist
April 18, 2024

Dr. Robyn Klein has been elected to the American Association for the Advancement of Science (AAAS) class of Fellows for her research in neuroscience
Announcement: Celebrating the 2024 Awards of Excellence recipients
April 11, 2024

Ensure your spot at the Awards of Excellence Dinner as we celebrate the deserving recipients of the 2024 awards.
Analysis identifies areas for improvement in the overall health of Canadians
April 11, 2024

Investigation by Dr. Saverio Stranges and others shows improvements in overall health of Canadians have stalled compared to other high-income countries.
Transforming care for transplant patients
April 10, 2024

Dr. Alp Sener is the inaugural holder of the Andrew Lazarovits Chair in Immunobiology and Transplantation. The new clinician-scientist position at Western and LHSC honours legacy of Dr. Andrew Lazarovits
Dr. Alp Sener named the inaugural Andrew Lazarovits Chair in Immunobiology and Transplantation
April 10, 2024
We are pleased to announce that Dr. Alp Sener, MD, PhD, FRCSC, has been named the inaugural Andrew Lazarovits Chair in Immunobiology and Transplantation at the Schulich School of Medicine & Dentistry, Western University, and London Health Sciences Centre (LHSC), effective March 1, 2024, to February 28, 2029.
Schulich Medicine & Dentistry researchers named Distinguished University Professors
April 09, 2024

Recognized for their leadership, research excellence and community service, Frank Beier, PhD, and Michelle Mottola, PhD, have been named Distinguished University Professors.
Funding helps young researcher tackle global challenges of AMR
April 08, 2024

Idowu Olawoye, PhD, is tackling drug-resistant bacteria with next generation tools. The early career researcher is the recipient of CIHR funding to support this vital work.
PhD candidate combines passion for research with teaching
April 04, 2024

PhD Candidate Amena Aktar knew early on that she wanted to pursue a career in science. Now the award-winning student is using her talents to help others.
In memoriam - Dr. Neil McKenzie
April 04, 2024
Flags will be lowered to half-mast today at London Health Sciences Centre’s (LHSC) Victoria and University hospitals in honour of Dr. Neil McKenzie, who passed away on March 25, 2024.
Western celebrates 2024 Green Award recipients
April 03, 2024

An award-winning teacher at Schulich Medicine & Dentistry and a pediatric ear, nose and throat surgeon at London Health Sciences Centre (LHSC), Dr. Julie Strychowsky has received a Western Green Award for her efforts to improve environmental sustainability in her life and practice.
Young researchers on frontlines of brain studies among recipients of early career funding
March 28, 2024

Taylor Schmitz, PhD, and Jibran Khokhar, PhD, are among a record 10 Western young researchers receiving funding to build teams and advance their projects.
In Memoriam – Dr. Godfrey Heathcote
March 27, 2024
It is with great sadness that we share the news of the passing of Dr. Godfrey Heathcote in Bayfield, Ontario on March 20, 2024.
Clinical neuroscientist awarded 2024 Ryman Prize for work on the "terrible three"
March 27, 2024

Dr. Vladimir Hachinski is being presented the international award by New Zealand Prime Minister Christopher Luxon for his contributions to advancing brain health and healthy aging
Announcement: 2024 Awards of Excellence - Windsor Campus Recipients
March 27, 2024

Let’s celebrate the 2024 Award winners —our staff, faculty and learners whose commitment and dedication to excellence in education across the Windsor campus have enriched our community.
Researchers a step closer to a cure for HIV
March 26, 2024

A new study, co-led by Eric Arts, PhD, shows a virus-like particle can effectively ‘shock and kill’ latent HIV reservoir in those living with chronic HIV, bringing us a step closer to a cure.
Measles, contagious yet preventable- outbreaks, symptoms, complications
March 22, 2024

With the resurgence of measles in Canada, Mansour Haeryfar, PhD, wrote a primer for The Conversation explaining the effectiveness of measles vaccines and remaining up-to-date with measles immunization.
Western strengthens collaborations with Makerere University in Uganda
March 22, 2024

Memorandum of understanding deepens the long-standing relationship with Uganda’s largest and oldest university, providing new opportunities for Schulich Medicine & Dentistry students and researchers and other Western faculties.
Medical startup secures seed funding to develop robotics system for colon cancer treatment
March 20, 2024

Featured in Rapport 2022, Saumik Biswas, PhD'20, co-founder, president and CEO and team have secured $2 million in funding for a platform technology that effectively scans for lymph nodes in cancerous tissues.
Funding sets stage for major innovations in biotherapeutics and translational research
March 13, 2024

A new centre for biotherapeutics research and support for researchers in better understanding brain function have been awarded new funding from the Canada Foundation for Innovation.
Targeting toxic bacteria among research projects to receive CIHR project funding
March 12, 2024

CIHR project grants will help Schulich Medicine & Dentistry researchers, like David Edgell and Dean Betts, create news answers to our health challenges.
Breaking barriers: Celebrating the pioneering women who pursued their medical dreams
March 07, 2024

Dr. Marie Jeanne Ferrari, BA’55, MD’59, may be a reluctant pioneer, but she stands as an example to a new generation of women in medicine who recognize her contributions.
New study expands understanding of brain blood flow and neurological disorders
March 07, 2024

Researchers developed an efficient non-invasive method map blood flow (perfusion) in the hippocampus at an unprecedented resolution.
Clinician-scientist candidate serves both patients and country with a smile
March 06, 2024

Not many would pair military boots with a lab coat, but to Jennifer Guo, the unexpected combo makes perfect sense.
Using micro-ultrasound to deliver targeted radiotherapy to patients with prostate cancer
March 05, 2024

Dr. Lucas Mendez, assistant professor in the Department of Oncology, has received funding to use micro-ultrasound to improve targeted radiation therapy
Leadership Announcement: Physical Medicine & Rehabilitation
March 04, 2024

We are pleased to announce Dr. Keith Sequeira's appointment in the Department of Physical Medicine & Rehabilitation as Chair at the Schulich School of Medicine & Dentistry, Western University, Physician Department Head at London Health Sciences Centre (LHSC), and Chief at St. Joseph’s Health Care London (St. Joseph’s).
Researchers revolutionizing understanding of nicotine’s effect on adolescent brain
February 29, 2024

Pioneering research delves into nicotine's neurotoxic impact on adolescents, linking it to future mood and anxiety disorders.
FAQ: Why are syphilis cases on the rise in Canada?
February 28, 2024

While the reasons for its increase are not fully known, Dr. Huma Saeed writes in The Conversation that prevention is key to individual health and slowing its spread.
Behind the Research: Examining the brain’s secrets
February 28, 2024

Western President Alan Shepard discusses the latest advances in neuroscience and cognition with Schulich Medicine & Dentistry Professors Lisa Saksida and Ravi Menon.
Neuroscience student works to further Alzheimer’s research and diversify student voices at Western
February 27, 2024

Dika Ojiakor spent his childhood devouring books that seemed too old for him. His curiosity has now led to research on Alzheimer’s at Robarts Research Institute.
Study finds children in marginalized communities more likely to experience cardiac arrests
February 26, 2024

New study examines how social determinants of health put children at risk of life-threatening event
Researcher joins global network to find vaccine for often-deadly Strep A
February 21, 2024
John McCormick, PhD, is part of a group that is spearheading a multi-institution network to research bacterial cause of sepsis and heart damage in children.
Announcement: Dr. Francisco Olea-Popelka re-appointed as Beryl Ivey Endowed Chair in One Health
February 21, 2024

I am pleased to announce that Dr. Francisco Olea-Popelka has been re-appointed as the Beryl Ivey Endowed Chair in One Health at the Schulich School of Medicine & Dentistry, Western University, effective January 1, 2024, to December 31, 2028.
Margaret Mutumba turns advocacy into action
February 20, 2024

Director of Western's Frugal Biomedical Innovations is committed to promoting health-care equity in neglected populations
Announcement: Dr. Robert Stein appointed as Associate Dean, Learner Experience
February 20, 2024

I am pleased to announce that Dr. Robert Stein has been appointed as Associate Dean, Learner Experience, at the Schulich School of Medicine & Dentistry, Western University, effective February 1, 2024, to January 31, 2029.
Exposure to cannabidiol (CBD) in pregnancy reduces heart function in young male offspring
February 16, 2024

New study sheds additional light on the safety of cannabis use, particularly CBD, during pregnancy.
Study explores why South Asians have higher rates of heart disease
February 14, 2024

Research data provides a previously unrecognized link to explain why South Asians develop early and aggressive heart disease.
Susceptibility to Long COVID increased by obesity, particularly in women
February 13, 2024

Schulich Medicine & Dentistry researchers demonstrate women with a high BMI are more susceptible to Long COVID.
Medicine combines love of science with helping people for Barton-Forbes
February 12, 2024

Dr. Michelle Barton-Forbes, associate professor in the Department of Paediatrics, shares her journey and advice for young women considering a career in science, technology, engineering and math (STEM).
Staff and students taking critical roles in enhancing the Black experience on campus
February 06, 2024

Schulich Medicine & Dentistry staff, faculty and students are playing major roles in two recently-funded initiatives designed to make Western a more welcoming place for current and future Black staff, faculty and students.
In memoriam: Dr. William (Bill) Miletic
February 06, 2024
It is with deep sadness that we announce the passing of Dr. William (Bill) Miletic on February 5, 2024, at the age of 64.
Resident alum on a mission to debunk menstruation myths and misinformation
February 01, 2024

With her latest book, Dr. Jen Gunter, who did her residency training in obstetrics and gynecology at Schulich Medicine & Dentistry, seeks to empower and inform people about the menstrual cycle.
Neuroscience student, football player tackles early stages of Alzheimer’s
January 31, 2024

Hayley Shanks may be a wide receiver for Western’s women’s football team, but when she is off the field, she’s tackling Alzheimer’s disease through her research.
Meet the researchers who are breaking new ground as Western Research Chairs
January 26, 2024

Schulich Medicine & Dentistry boasts five Western Research Chairs who are unravelling the mysteries of the brain, infectious diseases, breast cancer, disease-inhibiting enzymes and bringing Indigenous perspectives to bear on human health.
Expert Insight: Why invasive cases of Strep A are increasing and what to look for
January 23, 2024

Professor John McCormick, and Juan Manuel Diaz, postdoctoral associate, of the Department of Microbiology and Immunology, explain why we're seeing a jump in the number of people with serious illness caused by Strep A.
Making an impact through research, teaching and admissions
January 19, 2024

The Canadian Association for Medical Education honoured Schulich Medicine & Dentistry faculty and learners with awards to recognize their outstanding contributions to medical education.
$6.5 million grant awarded to build consortium for improving the lives of Crohn's patients
January 17, 2024

Western University and the Cleveland Clinic have received funding to build a consortium to develop clinical trial outcome tools for patients with Crohn's disease living with a permanent ileostomy.
In memoriam: Dr. Arthur John (Jack) Harris and Dr. Norman McFarlane
January 17, 2024
It is with deep sadness that we announce the passing of Dr. Arthur John (Jack) Harris and Dr. Norman McFarlane, and convey our condolences to their families and friends.
New online study explores link between healthy brains and bodies
January 15, 2024

Schulich Medicine & Dentistry neuroscientist Adrian Owen, PhD, partners with U.K. science museum in research driven by immersive video games
Next-generation 3D imaging has potential to revolutionize shoulder replacement surgery
January 11, 2024

Orthopedic Surgeon Dr. George Athwal, and his team at St. Joseph’s Health Care London, became the first in Canada and second in the world to use advanced 3D imaging in shoulder replacement surgery.
Schulich Medicine & Dentistry trailblazers earn national and provincial honours
January 10, 2024

From saving premature newborns to providing innovative care for the elderly, Schulich Medicine & Dentistry trailblazers have left an indelible mark on many critical areas of patient care.
Expert Insight: Neighbourhood amenities may have helped youth mental health and stress early in the pandemic
January 08, 2024

Schulich Medicine & Dentistry researchers investigated how the availability of neighbourhood amenities contributed to changes in youth mental health and stress levels during the first six months of the pandemic. Here's what they found.
